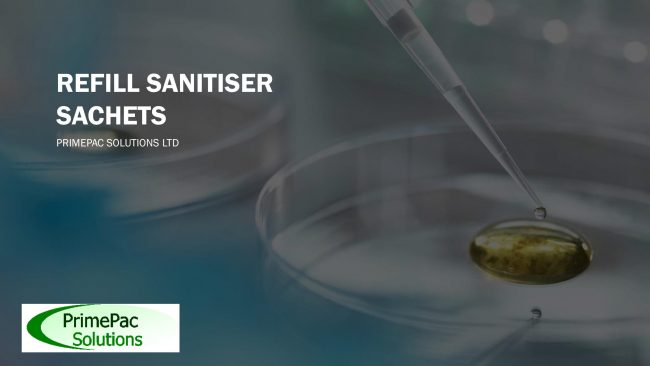

Capsule/Tablet counting
PrimePac Solutions Ltd has recently invested further in its capsule and tablet counting capabilities that improves the ability to accurately count and fill a range of fast moving consumer items at pace. This, combined with our secondary pack-off options such as labelling, shrink-sleeving or cartonning makes PrimePac your one-stop shop for bottle, jar, pouch or…